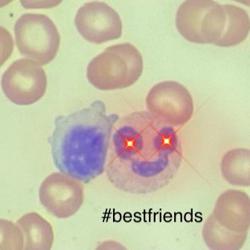

| Name |
Followers |
Following |
Registered |
D++
₿𝗶𝘁𝗰𝗼𝗶𝗻 𝗠𝗮𝘅𝗶𝗺𝗮𝗹𝗶𝘀𝘁 𝗖𝘆𝗽𝗵𝗲𝗿𝗽𝘂𝗻𝗸
☁️ 𝗖𝗼𝗱𝗶𝗻𝗴 𝗣𝗿𝗼𝗳𝗲𝘀𝘀𝗼𝗿 ☁️
💕 𝗖𝗼...
@dplusplus
|
9.7k |
395 |
Feb 6, 2021 |
|
|
42 |
136 |
- |
Devi_Ki Wongmo
A work in progress
Life is for Living
Per discussions have prepared...
@devirose
|
3.9k |
2.5k |
Feb 15, 2021 |
Issa Sanchez
ᴡᴡᴡ.ꜱᴡᴀɴʙɪᴛᴄᴏɪɴ.ᴄᴏᴍ/ᴇʟɪꜱꜱᴀ
🦢 ɢᴇᴛ $10 ᴏꜰ ꜰʀᴇᴇ ₿ᴛᴄ ⇧
ɪɴᴠᴇꜱᴛᴏʀ 📈 | ᴀᴄ...
@_elissasanchez_
|
186 |
73 |
Feb 15, 2021 |
|
|
720 |
104 |
Feb 13, 2021 |
|
|
18 |
88 |
Mar 20, 2021 |
MAGi .
♛♜ 📍𝕂ᵃşℍM𝔦ℝ 🏡 ♥️
#𝕭𝖎𝖙𝖈𝖔𝖎𝖓 ₿
ℂ𝕒𝕡𝕣𝕚𝕔𝕠𝕣𝕟
𝙒𝙞𝙨𝙝 𝙢𝙚 𝙤𝙣 26𝙩𝙝 𝙙𝙚𝙘🎂,
𝙖𝙛𝙩𝙚𝙧...
@arsu_26
|
29 |
27 |
- |
|
|
18 |
12 |
Jun 16, 2021 |
|
|
19 |
32 |
May 12, 2021 |
Shaaban
Fight on (USC). Twitter @Behairy313
Facebook group: https://www.faceb...
@behairy
|
648 |
402 |
Feb 6, 2021 |
Ed Ryan
📍Boston MA - Lawyer
Intellectually curious; relentless communicator...
@relentlesscmctr
|
1.8k |
1.4k |
Feb 7, 2021 |
Kathryn Clary
Bitcoin baby. 👶
If you are interested in Voyager, please consider u...
@clathrin
|
34 |
184 |
- |
|
|
178 |
114 |
Feb 12, 2021 |
Richard Black
Fitness advocate, Retail Investor, Art investor, and NTF enthusiast....
@richardblack
|
36 |
133 |
Mar 10, 2021 |
Kelly Perebyjnis
Half of a woman’s beauty should be a brain
Bitcoin enthusiast
Emai...
@kellyperebyjnis
|
161 |
51 |
Feb 13, 2021 |
Dr.Wejdan Arif
🇸🇦Born in London 🇬🇧
Assistant Professor ☢️
Neuroimaging🧠
@qamar33
|
1.1k |
1k |
Feb 22, 2021 |